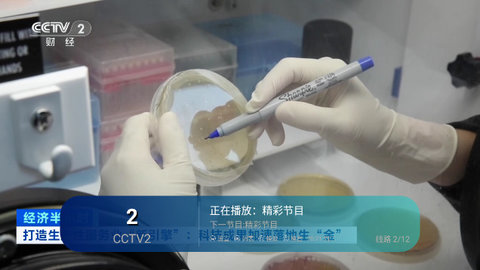
速看电视截图3

速看电视是一款可以适配安装在电视端之中的电视播放软件,直播视频播放更加轻松,高清流畅进行电视资源解锁,免费开始视频资源播放,涵盖了不同的视频节目,满足用户的不同需求,电视安装包的内置频道都可以在这里播放,多个路线都可以切换,流畅享受视频,感兴趣的用户千万不要错过!
1、首先在本站下载速看电视安装包,下载完成后将其存入U盘内
2、把U盘插入智能电视的USB插口,然后启动智能电视
3、打开电视后访问其通用设置,将“未知来源"这一项,设置为“允许”
4、然后找到U盘里下载后的应用
5、点击进行安装,安装后就可以查看该应用提供的内容了
1、不同的路线一键切换,保证视频的流畅播放体验
2、给用户更多的选择,简洁好用的界面设置,快速进行视频电视追剧
3、清晰度都可以任意调整,在其中享受不一样的电视作品
1、切换线路,适合不同的用户在这里筛选播放,视频浏览更加轻松
2、直播源可以切换,更多的资源都可以在这里直接观看,解决卡顿问题
3、视频文件的资源十分丰富,搜索资源非常丰富,优秀的资源免费解锁
1、美化直播播放体验,界面设计十分清爽,稳定高清直播视频免费观看
2、适合用户在这里体验,休闲时间享受电视追剧,轻松开始视频播放
3、电视频道十分丰富,数字电视都可以安装这款软件来开始追剧,一键享受视频魅力

洛克王国世界蹦蹦花养成攻略
2026-04-03 16:21
金铲铲之战S17四费卡汇总
2026-04-02 16:30
洛克王国世界燃薪虫有什么技能
2026-04-01 16:31
洛克王国世界新手PVE精灵推荐
2026-03-31 16:33
洛克王国世界圣羽翼王理论无限连技能阵容搭配
2026-03-30 16:33
客官里面请背包系统攻略
2026-03-29 16:47
梦幻新诛仙万剑青云怎么玩
2026-03-27 16:59
魔王城物语纪念品店玩法介绍
2026-03-26 16:15
无限暖暖万相境空鸣峡山君宝龛点位大全
2026-03-25 16:27
鸣潮隐藏任务寻猫大师怎么完成
2026-03-24 16:37
8.4
2人评论
请为应用评分:
评论内容需在5-200字之间~
0/200
素尘
2026-03-18 19:37:48
延长手机使用寿命还可以给手机降温
0
王四四
2025-08-24 20:35:52
海量缓存数据导致手机运行缓慢
0
历史日志